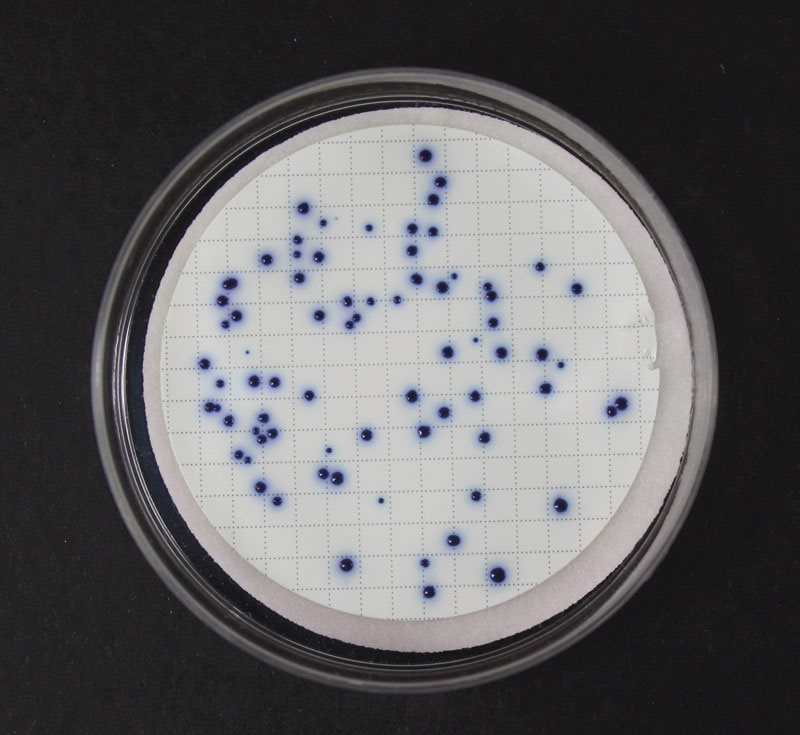
Milieu easydry gelose chromatique iso pour e.coli et coliforme 100 pcs

Gauss
Milieu easydry gelose chromatique iso pour e.coli et coliforme 100 pcs
Réf.
UGAP : 3664399
Réf.
Fournisseur : 339054
Réf.
Constructeur : 87500
Franco de port et d'emballage pour toutes les commandes supérieures à 80€ HT.
Produit ni repris ni échangé excepté en cas d’erreur du prestataire.
Produit ni repris ni échangé excepté en cas d’erreur du prestataire.
Points clés
Après avoir hydraté le milieu de culture, le milieu est prêt à l'emploi. Ce système est idéale pour les analyses microbiologiques de l'eau par la technique des membranes de filtration
Garantie
Garantie 0 Mois
Description
Après avoir hydraté le milieu de culture, le milieu est prêt à l'emploi. Ce système est idéale pour les analyses microbiologiques de l'eau par la technique des membranes de filtration
Caractéristiques
- Organisme cible
- E. coli et coliformes
- Classement dans le catalogue fournisseur
- microbiologie : analyses et mesures
- Type d'échantillon
- tous types
- Marque
- LIOFILCHEM
- Référence distributeur
- 339054
- Référence fabricant
- 87500
- Domaine de recherche
- microbiologie
- Fournisseur
- DOMINIQUE DUTSCHER S.A
- Type de produit
- milieu
- Soumis à carboglace
- non
- Vendu par
- 100 pièces
- Quantité
- N/A
- Code douanier
- 38210000
- Dimensions extérieures l. x pr. x h.
- 0,33 x 0,135 x 0,155 mm
- Nomenclature IFPEN
- NA.73
- Nomenclature Nacres
- NA.73
- Nomenclature CEA
- SGP01
- Nomenclature IRSN
- 273
- Nomenclature INSERM
- NA.NA73
- Nomenclature CNRS
- NA73
- Nomenclature CHU
- 18.601
- Nomenclature DGOS
- LG10AOOO
- Reprise en cas d’erreur client
- non
- Lieu de stockage
- France - 67 Bernolsheim
- Type d’application
- culture bactérienne
- Lieu de fabrication
- Italie